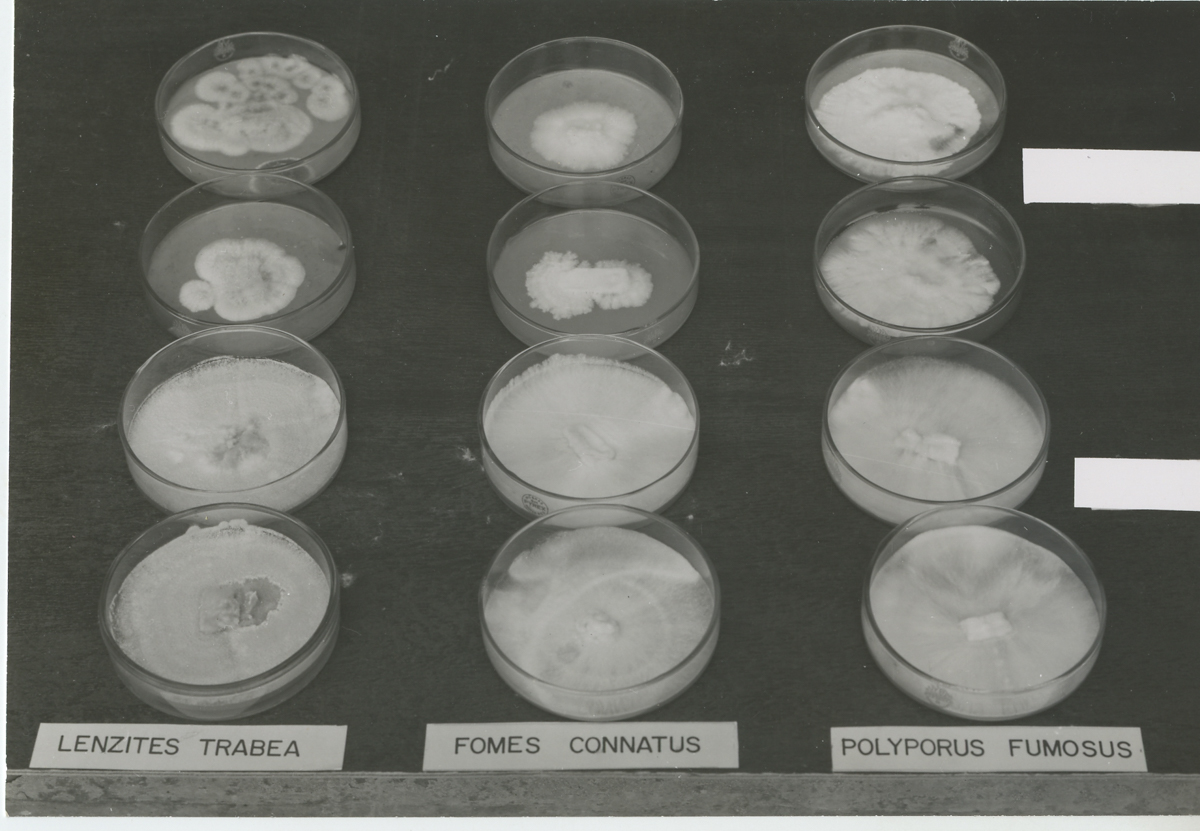

Documentos
Apresentação
Número de registro
01.002.0025.0068
Conteúdo
138 FOTOS. (+19 cópias). Foto 1 – Revelação de negativo. Linha horizontal. 4 imagens de um mesmo homem. Frente “Kodak 5063TX” P&B. 15,5x5,5cm. Foto 2 – Equipamento. Verso: “Foto. CR22. Ensaios Físicos e mecânicos. Maquina para ensaios. Pm-b”. P&B. 16x11cm. Foto 3 – Equipamento de vidro. Verso: “ 980”. P&B. 17x10,5cm. Foto 4 – Amostra vista de 4 formas. Frente: “ nº3”. Verso: “ Corpo de prova. Cenexos (?), para certificado oficial. 962”. P&B. 15x11cm. Foto 5 – 17x9cm. P&B. Amostra de 3 cortes de tronco. Verso: “964”. Foto 6 – 17x8cm. P&B. 5 amostras de madeira. Verso: “Foto. Corpo de provas. Expostos ao ataque de cupins (certificação de Brumosa (?)) Sr. Preservação de Mader. 963”. Foto 7 – 15x11cm. P&B. Duas peças de madeira. Frente: “1.2.S3”. Verso: “ 1004”. Foto 8 - 15x11cm. P&B. Duas peças de madeira. Frente: “1.2.D1”. Verso: “ 1005”. Foto 9 - 15x11cm. P&B. Duas peças de madeira. Frente: “1.2.D2”. Verso: “ 1006. Foto. Ensaio combustibilidade solidor E.Divisão.”. Foto 10 – 15x11cm. P&B. Duas peças de madeira. Frente: “1.2.D3”. Verso: “ 1007”. Foto 11 – 16,5x11cm. P&B. Três amostras de madeira. Verso: “Foto Corpo de prova anexo – (ensaio de cupim / luler(?).duratex s/a. 1008”. Foto 12 - 16,5x11cm. P&B. Três amostras de madeira. Frente: 1.7.0”. Verso: “Foto. Ensaio de atacabilidade de cupins. Ilegível. 1009”. Foto 13 - 16,5x11cm. P&B. Quatro amostras de madeira. Frente: “2.6.7.8”. Verso: “Foto 1010”. Foto 14 - 16,5x11cm. P&B. Três amostras de madeira. Frente: “5.6.8”. Verso: “Foto. Ensaio de atacabilidade de cupins. Ilegível. 1011”. Foto 15 - 16,5x11cm. P&B. Três amostras de madeira. Frente: 2.4.9”. Verso: “Foto. Ensaio de atacabilidade de cupins. Ilegível. 1012”. Foto 16 - 16,5x11cm. P&B. Quatro amostras de madeira. Frente: “1.2.5.7”. Verso: “Foto 1013”. Foto 17 - 16,5x11cm. P&B. Quatro amostras de madeira. Frente: “2.3.4.6”. Verso: “Foto ensaio sobre resistência a cupim. Ilegível. Duratex s/a. 1014. 1”. Foto 18 - 16,5x11cm. P&B. Quatro amostras de madeira. Frente: “1.8.5.7”. Verso: “1015”. Foto 19 - 16,5x11cm. P&B. Seis amostras de madeira. Frente: “1/J-T. 2/J-T. 3/J-F. 6/J-F. 3/J-Bb. 6/J-Bb. ”. Verso: “1018”. Foto 20 – Cópia da foto 19. Foto 21 - 16,5x11cm. P&B. Seis amostras de madeira. Frente: “1/C-T. 2/C-T. 1/1C-F. 2/1C-F. 1/1C-B. 2/1C-B”. Verso: “1017”. Foto 22 - 16,5x11cm. P&B. Seis amostras de madeira. Frente: “1/2C-B. 2/2C-B. 1/2C-F. 2/2C-F. 1/2C-T. 2/2C-T.”. Verso: “Foto. Corpo de provas atacado por cupins ent. Duratex s/c” 1016. 3 ilegível. Foto 23 - 16,5x11cm. P&B. Quatro amostras de madeira. Frente: “1.8.5.7”. Verso: “Foto Ensaio ilegível. 1015”. Foto 24 – 16x10cm. P&B. Três amostras de madeira. Frente: “S-1. S-2. S-3”. Verso: “Corpos de provas atacados por cupins. Duratex. 1019. 15-9-70”. Data provável: 15-9-1970. Foto 25 - 16x10cm. P&B. Três amostras de madeira. Frente: “B-1. B-2. B-3.”. Verso: “Foto corpos de provas atacados por cupins. 1020. Ilegível. 10-9-70”. Data provável: 15-9-1970. Foto 26. Cópia foto 25. Foto 27 – 16x10cm. P&B. Três amostras de madeira. Frente: “T-1. T-2. T-3.”. Verso: “1021.”. Foto 28 - 16x10cm. P&B. Três amostras de madeira. Frente: “4217/8. 4217/7. 421/9”. Verso: “Foto ensaio de atacabilidade de cupins. 1022. Ilegível. Duratex s/a”. Foto 29 – 16x10cm. P&B. Três amostras de madeira. Frente: “421/1. 4217/2. 4217/6. Verso: “Foto Ensaio de atacabilidade de cupins. 1023. Ilegível. Duratex s/a”. Foto 30 – 16x10cm. P&B. Três amostras de madeira. Frente: “421/3. 4217/4. 4217/8”. Verso: “Foto Ensaio de atacabilidade de cupins. 1024. Ilegível. Duratex s/a”. Foto 31 – Cópia da foto 30. Foto 32 – 16x10cm. P&B. Três amostras de madeira. Frente: “B.M.T” Verso: “Foto Poste para ensaio de penetração de preservativos. 1025”. Foto 33 – Cópia foto 32. Foto 34 – 15x7cm. P&B. Quatro frascos de vidro com tampas com amostras. Verso: “Foto conjunto de frascos contendo material atacado. Ensaio placa 5aa. MD. 951”. Foto 35 – 16x10cm. P&B. Dezesseis amostras. Frente: “1.2”. Verso: “ D.m. 950. Foto conjunto de placa Petri. Ensaio de tintas. Resistência de bolory(?). Paca prema s/a”. Foto 36 – 17x10. P&B. Doze amostras. Frente: “ Testemunhas. Extrato. Polyporus fumosus. Fomes connatus. Lenzites trabea. 1.2”. Verso: “957. Estrtativos de madeira com atividades antifúgicas [sic]”. Foto 37 – Cópia da foto 36. Foto 38 – Cópia da foto 36. Foto 39 – 17x9cm. P&B. Seis amostras. Frente: “Polyporus Fumosus. Fomes Cannatus. Lenzites Trabea. Extrato. Testemunhas”. Verso: Foto 958. Progeto [sic] sobre estudos de estudos de extrativos com atividade antifúngica”. Foto 40 – 17x9cm. P&B. Seis amostras. Frente: “Polyporus Fumosus. Fomes Cannatus. Lenzites Trabea. Extrato. Testemunhas”. Verso: “Foto 959”. Foto 41 – Cópia foto 40. Foto 42 – 17x9cm. P&B. Seis amostras. Frente: “Polyporus Fumosus. Fomes Cannatus. Lenzites Trabea. Extrato. Testemunhas”. Verso: “Foto 956”. Foto 43 – 16x10cm. P&B. Nove amostras. Frente” 1.2.Testemunhas.Polyporus fumosus. Fomes Connatus. Lenzites Straita”. Verso: “960. Foto. Estrativos de madeira com atividade autifugica [sic]”. Foto 44 – Cópia da foto 43. Foto 45 – 16x10cm. Quatro amostras. Frente: “Lenzites trabea. Fomes connatus. Polyporus fumosus. Extrato. Testemunhas”. Verso “961”. Foto 46 – Cópia da foto 45. Foto 47 – 16x10,5cm. Doze amostras. Frente: “Lenzites trabea. Fomes connatus. Plyporus fumosus”. Verso: “Foto ensaio biológico de estrato de madeira. (Progeto [sic] autifingicos de madeira nacional. Extrativo de madeiras. 1031”. Foto 48. 16x10,5cm. P&B. Sete amostras. Verso: “Foto. Ensaio de resistência ao ataque de cupins. Relatório de Duratex s/a. S madeira. 983”. Foto 49 – 17x11cm. P&B. Quatro amostras. Verso: “Foto. Paineis Brasito p. ilegível. Ensaio combustibilidade. Ensaio oficial para ilegível. 984”. Foto 50 – 9x16cm. P&B. Uma amostra. Verso: “985-985”. Foto 51 – 11x12cm. Duas amostras. Frente: “1.2”. Verso:” Foto material submetido a ensaio de combustibilidade. Sociedaade ilegível. Tubos Brasilite. 986”. Foto 52 – 11x10cm. P&B. Duas amostras. Verso: “Foto. Paineis submetidos a ensaoi de flamabilidade. 987. Md, 21-10-70”. Data provável: 1970. Foto 53 – Cópia foto 52. Foto 54 – 15x12cm. P&B. Duas amostras. Verso: “Foto painéis submetido a ensaio de flamabilidade. 988. 21-10-70”. Data provável 21-10-1970. Foto 55 – 10x16,5cm. P&B. Três amostras de madeira. Frente: “B.M.T”. Verso: “Foto. Ensaio de penetração de preservativo. Suprimido ou grafia não compreendida. 989”. Foto 56 – Copia foto 55. 10x16cm. P&B. Três amostras. Verso: “Foto. Ensaio biológico. 990. Preservação madeira”. Foto 57 – 11x13cm. P&B. Frente: “T.A.E.5.10.1.2.3”. Verso: “Doze amostras. De um conjunto de placas de cetil. Ensaio suprimido ou grafia não compreendida para seção de química de madeira, prog. Extrativos com propriedade autufungico. 992”. Foto 58 – 8x17cm. P&B. Três amostras de madeira. Frente: “4.5.6”. Verso: “Foto Postes de madeira. Creosatado. Ensaio de penetração de preservativo. 992.993”. Foto 59 – Cópia da foto 58. Foto 60 – 8x17cm. P&B. Três amostras de madeira. Frente: “B.M7.T”. Verso: “ Foto. Poste para ensaio de penetração de preservativo. Ilegível. 996”. Foto 61 – 8x17cm. P&B. Três amostras de madeira. Frente “B.M6.T”. Verso: “Foto. Poste para ensaio de penetração de preservativos. 995”. Foto 62 – Cópia da foto 61. Foto 63 – 8x17cm. P&B. Três amostras de madeira. Frente: “B.M3.T”. Verso: “Foto. Poste para ensaio de penetração de preservativo. 994”. Foto 64 – 11x17cm. P&B. Nove amostras. Frente: “Lenzites trabea. Fomes connatus. Polyporus fumosus. Angico. Extrato. Testemunhas”. Verso: “Foto. Placas de Petri. (Proj. Centifunfigas Madeira). 997. MD”. Foto 65 – 12x17cm. P&B. Nove amostras. Frente: “ Lenzites trabea. Fomes connatus. Polyporus fumosus. Testemunhas. Extrato. Óleo”. Verso: “Foto. Placas de Petri. (Proj. Centifungicas madeira). 998”. Foto 66 – 11x16cm. P&B. Duas amostras. Verso: “Corpo de prova submetido ao ensaio Schyter, (lute suprimido ou grafia não compreendidaquímica _ 999. MD”. Foto 67 – 11x16cm. P&B. Duas amostras. Verso: “Foto corpo de prova ilegível. Ao ensaio schyter. Suprimido ou grafia não compreendidaquímica. 1000 MD”.Foto 68 – 11x16cm. P&B. Duas amostras. Verso: “Foto ensaio de combustibilidade solidor. Divisão s/a. 1001”. Foto 69 – 11x15. P&B. Duas amostras. Frente: “1.2.S2”. Verso: “ Foto. Ensaio de combustibilidade suprimido ou grafia não compreendidae divisão s/a. 1002”. Foto 70 - 11x15. P&B. Duas amostras. Frente: “1.2.S2”. Verso: “ Foto. Ensaio de combustibilidade suprimido ou grafia não compreendidae divisão s/a. 1003”. Foto 71 - 11x15. P&B. Duas amostras. Frente: “1.2.S4”. Verso: “1003”. Foto 72 – 11x16,5cm. P&B. Quatro amostras. Verso: “Foto. Ensaio de combustibilidade. Ilegível. 95”. Foto 73 – 10x16cm. P&B. Aparelho de marca Heizung, vista frontal. Verso: “Foto. Aparelhor(?). Anariador (?). Importações. Kail. Ilegpivel, 976”. Foto 74 - 10x16cm. P&B. Aparelho de marca Heizung, vista do verso. Verso: “Foto. Aparelhos. Aviador. Importações. Kail. Ilegpivel, 977”. Foto 75 – 9,5x15cm. P&B. Aparelho, vista lateral. Verso: “Aparelhos ilegível. 978”. Foto 76 – 9x10cm. P&B. Doze amostras. Frente: “ 1.2.3.A.T.E.5.10”. Verso: “Foto. Placas de Petri. Projeto de pesquisa científica de madeira. Extrativo de madeira. MD. 1026”. Foto 77 – 9x16cm. P&B. Equipamento metálico de dois corpos. Verso: “Foto. Aparelhos ilegível. 979”. Foto 78 – 10x16cm. P&B.Três amostras. Frente: “T1.T2.T3”. Verso: “Foto. Corpo de provas suprimido ou grafia não compreendidaataque de cupins. Ilegível. 1027”. Foto 79 – 11x16cm. P&B. Vinte amostras. Frente: “1.2.3.4.1.2.3.4.5.6”. Verso: “Foto de placas de pretrinoculadas c/ fuisor. Ppodrecedores. Progeto [sic] de pesquisa. Estudo da resistência material das madeiras nacionais ao podrecimento. MD 946”. Foto 80 – 10x16cm. P&B. Três amostras. Frente: “B-1.B2.B3”. Verso: “Foto. Corpo de provas. Ataque de cupins. 1028”. Foto 81 – 10x16cm. P&B. Três amostras. Verso: “ Foto. Corpos de provas ao ataque. 1029”. Foto 82 – 11,5x13cm. P&B. Doze amostras. Frente”E.T.A.1.2.3”. Verso: “Foto. Relatório Capes, Bride. Bid. Extrativo de madeira. 1030”. Foto 83 – 9x16cm. P&B. Dois equipamentos de extremidades pontiagudas com etiqueta metálica indicando “madesco”. Verso: “Lançadeiras. Cert.of.164389.MD905. 18/22/59”. Foto 84 – 11,5x17cm.P&B. Vista pontual de obra com parede, escorras, entulhos. Verso: “Relatório 2850. 17/12/58. MD 904. Choyra (?) 3”. Foto 85 – 12x16cm. P&B. Dois caixotes com a inscrição “Caracu”. Verso: “165447. MD906. Engradados para transporte de cerveja de garrafas (caracu). Foto 86 – 22,5x6cm. P&B. Imagem de um machado de cabo longo. Verso: “MD 919”. Foto 87 – 17x7,5. P&B. Pedaço de cabo de madeira com rompimento em duas partes. Verso: “MD 920”. Foto 88 – 9x17cm. P&B. Três amostras de madeira. Frente: “1.2.3”. Verso: “Foto para certificação (ensaio da firma Camargo Correia 964”. Foto 89 – 8x16cm. P&B. Três amostras. Verso: “Foto. Corpo de provas (ensaio de impermeabilização, industriais mudial s/a). 965”. Foto 90 – 8x16cm. P&B. Três amostras. Verso: “Foto. Corpo de provas (ensaio de impermeabilização, industriais mudial s/a). 966”. Foto 91 – 10x15cm. P&B. Duas amostras de madeira. Frente: “7”. Verso: “Foto. Para ilustração de vertificado entre Duratex 967”. Foto 92 – 14x10cm. P&B. Duas amostras de madeira. Frente: “23.7”. Verso: “Foto. Para ilustração de certificado. Duratex s/a. 968”.Foto 93 – Cópia da foto 92. Foto 94 – 10x15cm. P&B. Duas amostras de madeira. Frente: “23”. Verso: “Foto. Para ilustração do certificado. Duratex. S/A. 969”. Foto 95 – 16,5x11cm. P&B. Quatro amostras. Verso: “975”. Foto 96 – 8x10cm. P&B. Uma amostra. Frente: “1”. Verso: “Foto dos resultados do estudo de tospides (?) do pentadoro (?) deira de iodo e suporte de cobre sobre o loroplylhun trabemu (?). 970”. Foto 97- Cópia foto 96. Foto 98 - 8x10cm. P&B. Uma amostra. Frente: “2”.Verso: “970”. Foto 99 – Cópia da foto 98. Foto 100 - 8x10cm. P&B. Uma amostra. Frente: “3”. Verso: “971”. Foto 101 - 8x10cm. P&B. Uma amostra. Frente: “3”. Verso: “972”. Foto 102 - 8x10cm. P&B. Uma amostra. Frente: “4”. Verso: “971”. Foto 103 – Cópia da foto 102. Foto 104 - 8x10cm. P&B. Uma amostra. Frente: “5”. Verso: “972”. Foto 105 - 8x10cm. P&B. Uma amostra. Frente: “6”. Verso: “972”. Foto 106 - 8x10cm. P&B. Uma amostra. Frente: “7”. Verso: “973”. Foto 107 - 8x10cm. P&B. Uma amostra. Frente: “8”. Verso: “973”. Foto 109 - 8x10cm. P&B. Uma amostra. Frente: “9”. Verso: “Foto do resultado do estudo da toxidos do pentaclorofeido de sódio de sulfato de cobra sobre o glovo ilegível. 974”. Foto 110 - 8x10cm. P&B. Uma amostra. Frente: “10”. Verso: “Foto do resultado do estudo da toxidos do pentaclorofeido de sódio de sulfato de cobra sobre o glovo ilegível. 974”. Foto 111 – 11x7,5cm. P&B. Equipamento. Verso: “Foto Fotografia para suprimido ou grafia não compreendidade certificado oficial. 284721. 953”. Foto 112 – Cópia foto 111. Foto 113 – 11x,5cm. P&B. Foto de equipamento com amostra de madeira sendo prensada. Frente: “ C-50.3”. Verso: “Foto documentação do certificado oficial. 953.954.956. 287033”. Foto 114 – 11x7,5cm. P&B. Equipamento de analise de madeira. Verso: “C.O. 284721. 952”. Foto 115 – 12x16,5cm. P&B. Equipamento. Verso: “Ensaio mecânico de telha de madeira modulada. MD 899. Madeirite. Certif. 160832. MD899. 3/9/59”. Foto 116 – 17x11,5cm. P&B. Equipamento para ensaio mecânico de telha de madeira modulada. Verso: “MD 900. Idem cerdor 160.832”. Foto 117 – 15,5x18,5cm. P&B. Dois equipamentos grandes de chão em galpão. Verso: “Idem cod. 160.832. MD 898”. Foto 118 – 14,5x19cm. P&B. Equipamento analisando amostra de madeira. Verso: “b.0161529. 1 de MD 902”. Foto 119 – 16,5x19cm. P&B. Oito amostras de madeira. Frente: “1.2.3.4.5.6.7.8”. Verso: “161.529. MD 903”. Foto 120 – 15,5x11,5cm. P&B. Amostras de madeiras empilhadas. Verso: “ MD 910”. Foto 121 – 15,5x11,5cm. P&B. Dormente. Frente: “Usina de preservação de madeiras, IPT”. Verso: “MD 909”. Foto 122 – 15,5x11,5cm. P&B. Dormente. Frente: “Usina de preservação de madeiras, IPT”. Verso: “MD 908”. Foto 123 – 15,5x11,5cm. P&B. Dormente. Frente: “Usina de preservação de madeiras, IPT”. Verso: “ Recuperação de dormente por grampeamento. MD 907”. Foto 124 – 22x7,5cm. P&B. Oito amostras de madeira. Frente: “ 1.2.3.4.5”. Verso: “MD 913. C.O. 170.001. Dormente tratados”. [sic] Foto 125 – Cópia da foto 124. Foto 126 – 18x12,5cm. P&B. Amostra de duas madeiras com marcações numéricas. Verso: “MD 910. MD 911. Ensaio de apodrecimento ilegível. Teste de preservativo. Ilegível”. Foto 127 – 11x13,5. P&B. Caixa de madeira. Frente: “Oleo saúde”. Verso: “MD 916”. Foto 128 - 11x13,5cm. P&B. Caixa de madeira. Frente: “Oleo saúde”. Verso: “MD 917”. Foto 129 – 10x16cm. P&B. Caixa de madeira. Verso: “MD 918. 3.3034. Caixa de madeira”. Foto 130 – 117x11cm. P&B. Equipamento em galpão analisando telha modulada. Verso: “ MD 921”. Foto 131 – 22,5x14cm. P&B. Doze amostras de madeira. Frente: “ 1.2.11.12.21.22.36.37.38.39.40.41”. Verso: “Dois lotes de corpo de prova. B. 1229. MD 922”. Foto 132 – 22,5x14cm. P&B. Doze amostras de madeira. Frente: “.2.11.12.21.22.26.27.28.29.40”. Verso: “MD 923. B3229”. Foto 133 – 11,5x12cm. P&B. Uma amostra de madeira. Frente: “4”. Verso: “G0192.978. MD 924”. Foto 134 – 11,5x12cm. P&B. Uma amostra de madeira. Frente: “3”. Verso: “MD 925. Go 192978. Sequentes de morão preservado”. Foto 135 – 15,5x12cm. P&B. Duas caixas de madeira. Frente: “Óleo Lirio”. Verso: “MD 927”. Foto 136 – 15,5x12cm. P&B. Duas caixas de madeira. Frente: “Óleo Lirio”. Verso: “MD 926”. Foto 137 – 16x11cm. P&B. Caixa de madeira com tampa entreaberta. Verso: “ MD 928. R 3316”. Foto 138 – 11x14,5cm. P&B. Caixa de madeira. Verso: “Md 929. R 3316”. Foto 139 – 16x12cm. P&B. Uma caixa de madeira escorrega por uma rampa e outras estão no chão carregadas de um objeto circular. Verso: “MD 931. B 3316”. Foto 140 – 11x,12,5cm. P&B. base de madeira com 4 hastes verticais. Verso: “B3316. MD 930”. Foto 141 – 22x16cm. P&B. Equipamento em galpão analisa telha modulada. Verso: “Int. ilegível. MG 932”. Foto 142 – 16x9cm. P&B. Duas peças cumpridas com escala indicada. Frente: “1.2”. Verso: “Preservação de madeira. Certificado oficial nº 207,238. Verificação de eficácia de processo de tratamento preservativo em poste de eucalipto. MD 933”. Foto 143 – 10,5x10,5cm. P&B. Amostra de madeira. Verso: “172285.172255.MD915”. Foto 144 – 18x12cm. P&B. Equipamento em galpão. Verso: “Eucalipto na serra do fita mostrando abertura. MD 934”. Foto 145 – 17x12cm. P&B. Vinte amostras. Frente: “3.1.2.3.4”. Verso: “Ensaio interno – provas microbedógicas de atividade antifúngica de diferentes tintas. 935”. Foto 146 – 17x12cm. P&B. Vinte amostra. Frente: “ 2.1.3.4”. Verso: “Ensaio interno. Provas microbedógicas de atividade antifúngica de diferentes tintas. 937”. Foto 147 - 17x12cm. P&B. Vinte amostra. Frente: “1.1.2.3”. Verso: “Ensaio interno. Provas microbedógicas de atividade antifúngica de diferentes tintas. 936”. Foto 148 – 21x15cm. P&B. Vinte amostras. Frente: “1.1.2.3.4”. Verso: “Ensaio interno. Provas microbedógicas de atividades antifúngica de diferentes tintas. 938.+” Foto 149 – 21x15cm. P&B. Vinte amostra. Frente: “2.1.3.4”. Verso: “Ensaio interno. Provas microbedógicas de atividade antifúngica de diferentes tintas. 939”. Foto 150 – 21x15cm. P&B. Vinte amostra. Frente: “3.1.3.4”. Verso: “Ensaio interno. Provas microbedógicas de atividade antifúngica de diferentes tintas. 940”. Foto 151 – 21x15cm. P&B. Vinte amostra. Frente: “1.1.3.4”. Verso: “Ensaio interno. Provas microbedógicas de atividade antifúngica de diferentes tintas. 941”. Foto 152 – 21x15cm. P&B. Vinte amostra. Frente: “2.1.3.4”. Verso: “MD 942”. Foto 153 – 21x15cm. P&B. Vinte amostra. Frente: “3.1.3.4”. Verso: “MD 943”. Foto 154 – 13,5x11,5cm. P&B. Treze amostras de madeira com algumas marcações numéricas. Verso: “Foto material apodrecido retirado da torre de refrigeração. Retimaria. Ilegível. MD 944”. Foto 155 – 22,5x13,5cm. P&B. Quatro linhas com doze amostras cada. Verso: “1 chapa. Ensaio de resistência natural. A. Firma Planesa. MD. 944”. Foto 156 – 23x17cm. P&B. Equipamento em galpão. Verso: “Ensaio mecânico dormentes ilegível. 161529. MD 901”. Foto 157 – 23x15cm. P&B. Teste em viga dentro de um galpão. Frente: “Ensaio de flexão estática viga laminada colada vão 4,50m carga para viga 1500kg. Verso: “Foto Viga de dimesão estrutura ensaio flexão estática. MD 948”.
Subgrupo
Suporte
Gênero
Data
Sem data
Dimensão
Dimensões variadas indicadas na descrição de cada item, na coluna L
Nível de descrição
Tipologia
Técnica de registro
Formato
Número de Itens do conjunto
001
Idioma
Procedência
Estado de conservação
Bom